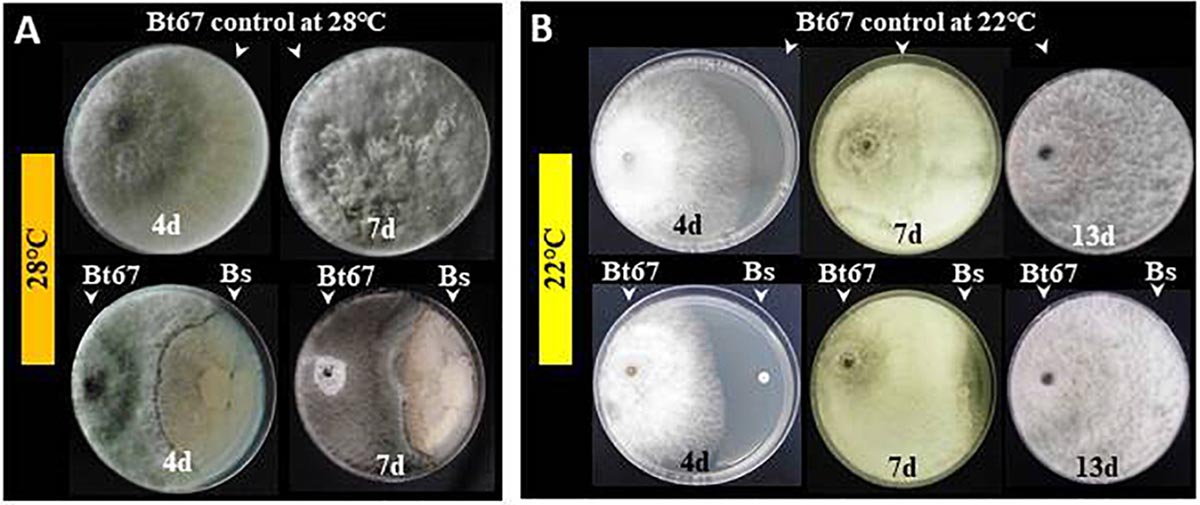
Bacteriën als wapen tegen houtschimmels - WijnWetenschap

Is Een Schimmel Een Bacterie

Heb je je ooit afgevraagd wat het verschil is tussen schimmels en bacteriën? Veel mensen verwarren deze twee microscopische organismen vaak, maar ze zijn eigenlijk heel verschillend. Dit artikel is bedoeld voor iedereen die nieuwsgierig is naar biologie, van studenten tot huisvrouwen, en wil begrijpen wat schimmels zijn en hoe ze verschillen van bacteriën. We gaan dieper in op de biologische kenmerken, verschillen en de impact die beide organismen op ons leven hebben.
Schimmels en Bacteriën: Twee Verschillende Werelden
Laten we meteen ter zake komen: nee, een schimmel is geen bacterie. Ze behoren tot verschillende rijken van het leven, net zoals planten en dieren dat doen. Om dit beter te begrijpen, duiken we dieper in hun definities en eigenschappen.
Wat zijn Schimmels?
Schimmels behoren tot het rijk van de Fungi. Ze zijn eukaryote organismen, wat betekent dat hun cellen een duidelijke celkern (nucleus) bevatten waarin het genetisch materiaal is opgeslagen. Dit is een cruciaal verschil met bacteriën. Schimmels kunnen zowel eencellig (zoals gist) als meercellig (zoals paddenstoelen en schimmels die je op brood ziet) zijn.
Must Read
Enkele kenmerken van schimmels:
- Eukaryote cellen: Bevatten een celkern en andere organellen.
- Celwand: Gemaakt van chitine, een complex koolhydraat.
- Voeding: Heterotroof, wat betekent dat ze organische stoffen nodig hebben als voedselbron. Ze voeden zich door absorptie.
- Reproductie: Kan zowel seksueel als aseksueel plaatsvinden via sporen.
- Diversiteit: Enorme diversiteit aan vormen, maten en leefomgevingen.
Denk aan de blauwe schimmel op oud brood. Die wollige, pluizige structuur is typisch voor schimmels. Of de heerlijke smaak van een stuk brie, die ook door schimmels wordt gevormd. Schimmels zijn dus niet alleen maar slecht; ze spelen ook een belangrijke rol in ons ecosysteem en in de voedselproductie.

Wat zijn Bacteriën?
Bacteriën behoren tot het rijk van de Monera (of Bacteria). Ze zijn prokaryote organismen, wat betekent dat ze geen celkern hebben; hun genetisch materiaal drijft los in het cytoplasma. Dit fundamentele verschil in celstructuur is het meest belangrijke verschil tussen schimmels en bacteriën.
Enkele kenmerken van bacteriën:

- Prokaryote cellen: Geen celkern of andere membraan-gebonden organellen.
- Celwand: Gemaakt van peptidoglycaan, een ander complex koolhydraat dan chitine.
- Voeding: Kunnen zowel heterotroof (zoals schimmels) als autotroof zijn (zelf voedsel produceren door fotosynthese of chemosynthese).
- Reproductie: Aseksueel door binaire deling (celdeling).
- Diversiteit: Grote diversiteit in vorm (bolvormig, staafvormig, spiraalvormig) en metabolisme.
Bacteriën zijn overal om ons heen: in de lucht, in de bodem, in ons lichaam. Sommige bacteriën zijn essentieel voor onze gezondheid, zoals de bacteriën in onze darmen die helpen bij de vertering. Andere bacteriën kunnen ziekten veroorzaken, zoals streptokokken die keelontsteking veroorzaken.
Belangrijke Verschillen Uitgelicht
Om de verschillen tussen schimmels en bacteriën echt helder te krijgen, vatten we de belangrijkste punten samen:
- Celstructuur: Schimmels zijn eukaryoot met een celkern, bacteriën zijn prokaryoot zonder celkern.
- Celwand: Schimmelcelwanden bevatten chitine, bacteriecelwanden bevatten peptidoglycaan.
- Grootte: Schimmelcellen zijn over het algemeen groter dan bacteriecellen.
- Reproductie: Schimmels kunnen seksueel en aseksueel reproduceren, bacteriën reproduceren meestal aseksueel.
- Complexiteit: Schimmels zijn complexer van structuur dan bacteriën, met organellen en een celkern.
Stel je voor dat je een huis bouwt. Schimmels zijn als huizen met meerdere kamers (organellen) en een hoofdkamer (celkern) waar de plannen (genetisch materiaal) bewaard worden. Bacteriën zijn daarentegen eenvoudiger gebouwen met één open ruimte waar alle functies plaatsvinden.
De Impact op Ons Leven
Zowel schimmels als bacteriën spelen een cruciale rol in ons leven, zowel positief als negatief.
Positieve aspecten:
- Schimmels:
- Voedselproductie: Gist voor brood en bier, schimmels voor kaasproductie (brie, camembert).
- Medicijnen: Penicilline, een belangrijk antibioticum, wordt geproduceerd door de schimmel Penicillium.
- Afbraak: Schimmels helpen bij de afbraak van organisch materiaal in de natuur.
- Bacteriën:
- Spijsvertering: Darmbacteriën helpen bij de vertering en productie van vitamines.
- Voedselproductie: Bacteriën worden gebruikt bij de productie van yoghurt, kaas en zuurkool.
- Stikstoffixatie: Sommige bacteriën zetten stikstof uit de lucht om in een vorm die planten kunnen gebruiken.
Negatieve aspecten:
- Schimmels:
- Infecties: Voetschimmel, ringworm, candida-infecties.
- Voedselbederf: Schimmel op brood, fruit en andere voedingsmiddelen.
- Allergieën: Schimmelsporen kunnen allergische reacties veroorzaken.
- Bacteriën:
- Infecties: Keelontsteking, longontsteking, voedselvergiftiging.
- Bedreiging voor drinkwater: Verschillende bacteriën kunnen waterbronnen vervuilen.
- Antibioticaresistentie: Een groeiend probleem waarbij bacteriën resistent worden tegen antibiotica.
We leven in een constante interactie met zowel schimmels als bacteriën. Het is belangrijk om te begrijpen hoe ze werken, zodat we onszelf kunnen beschermen tegen schadelijke effecten en kunnen profiteren van hun nuttige eigenschappen.

Hoe zit het met Virussen?
Nu we de verschillen tussen schimmels en bacteriën hebben behandeld, is het de moeite waard om kort virussen te noemen. Virussen zijn nog kleiner en eenvoudiger dan bacteriën. Ze zijn geen cellen en hebben levende cellen nodig om zich te vermenigvuldigen. Virussen kunnen zowel schimmels, bacteriën als dieren en planten infecteren. Het belangrijkste is dat virussen helemaal verschillen van bacteriën en schimmels.
Conclusie: Begrijpen is Belangrijk
Het is cruciaal om te onthouden dat schimmels en bacteriën twee fundamenteel verschillende soorten organismen zijn. Ze verschillen in celstructuur, voortplanting en functie. Hoewel ze beide zowel positieve als negatieve effecten op ons leven kunnen hebben, is het belangrijk om hun verschillen te begrijpen om effectieve strategieën te ontwikkelen voor het bestrijden van schadelijke organismen en het benutten van hun voordelen.
Hopelijk heeft dit artikel je geholpen om de verschillen tussen schimmels en bacteriën beter te begrijpen. Kennis is macht, en door meer te leren over de wereld om ons heen, kunnen we betere beslissingen nemen voor onze gezondheid en ons milieu. Blijf nieuwsgierig en blijf leren!
















